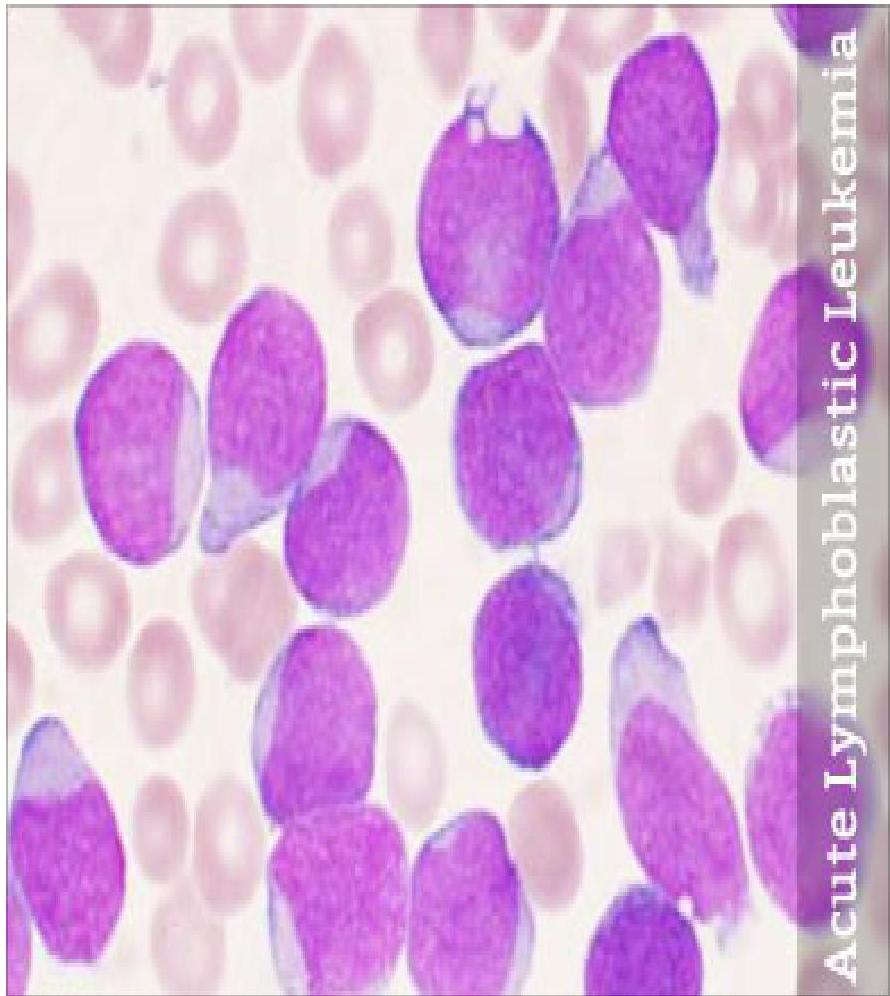
img-13.jpeg

LEUKEMIAS
BY DR WAQAR ALI
NORMAL HEMATOPOEISIS IN BONE MARROW


DEFINITION
Leukemia is a malignant neoplasm (cancer) of the WBCs (or their precursors) in the bone marrow.
There is an overproduction of these cells and they are “functionally abnormal”.
CLASSIFICATION OF LEUKEMIAS

COMPARISON OF ACUTE & CHRONIC LEUKEMIAS
Acute Leukemias:
- a. Arise from precursors of WBCs
- b. Symptoms develop quickly & progression is rapid
- c. Leukemic cells are immature looking blast cells
Chronic Leukemias:
- d. Arise from mature WBCs
- b. Disease progresses slowly, so symptoms occur after a long time
- c. Leukemic cells are mature looking. They are not called blast cells
ABBREVIATIONS OF LEUKEMIA TYPES
- A.L.L. : Acute Lymphoblastic Leukemia
- C.L.L. : Chronic Lymphocytic Leukemia
- A.M.L. : Acute Myeloblastic/Myeloid Leukemia
- C.M.L. : Chronic Myeloid Leukemia
PROGRESSION CHARACTERISTICS
-
Acute leukemias are rapidly growing, so if not treated early, they can cause death within a few weeks or months.
-
Chronic leukemias are slow growing and don’t cause death quickly.
ACUTE LYMPHOBLASTIC LEUKEMIA (A.L.L.)
DEFINITION OF A.L.L.

- It is a malignancy of lymphoblasts (a precursor of lymphocytes).
- There is overproduction of immature & abnormal lymphoblasts which do not mature into B & T lymphocytes.
B lymphocyte T lymphocyte
PATHOGENESIS
- Due to genetic damage in the lymphoblast, there is uncontrolled production of these cells.
- Excess lymphoblasts which are produced are the leukemic cells (cancer cells). They don’t mature into normal lymphocytes.
- These leukemic cells infiltrate the marrow & replace the normal RBC, WBC & platelets.
- They come into the blood & spread to other organs also.
GENERAL POINTS
1) Age Group:
- Mostly seen in children (peak is between 2-5 years)
- Second peak occurs in old age (above 50)
2) Associated Conditions:
- Increased risk in Down’s syndrome patients
3) Treatment Response:
- In children, the response to treatment is very good (90% cure rate)
SIGNS & SYMPTOMS (S/S)
- General weakness, fatigue (due to anemia)
- Recurrent infections (due to low numbers of normal WBCs). Fever is the most common presentation.
- Bleeding, easy bruising (due to thrombocytopenia)
- CNS involvement (headache, cranial nerve palsies, etc.)
- Enlarged nodes, hepatomegaly, splenomegaly
DIAGNOSIS

1) Complete Blood Count (CBC):
- Anemia
- Low platelets
- Very high WBC count (very high lymphoblasts)
2) Peripheral Smear:
- Excess lymphoblasts which are large abnormal cells with large nucleus & very little cytoplasm
3) Bone Marrow Biopsy:
- Shows excess lymphoblasts (more than 30% of marrow cells are abnormal lymphoblasts)

4) Flow Cytometry:
- Cancer cells have certain abnormal antigens on their surfaces which we can detect in the lab by flow cytometry.
- In ALL, TdT antigen is positive on the cell surface.
5) Imaging:
- After diagnosis, CT scan is done to find any metastases in other body organs.
TREATMENT
MAINLY CHEMOTHERAPY
Drugs Used: Z
- Vincristine
- Dexamethasone
- Asparaginase
- Daunorubicin
- Cytarabine
Mnemonic: Very Dark And Dirty Clothes (VDADC)
HOW CHEMO IS GIVEN
- Induction phase
- Consolidation phase
- Maintenance phase
CHEMOTHERAPY ADMINISTRATION METHOD
- Chemo in cancers is given through a port-a-cath

TREATMENT PHASES
1) Induction Phase:
- This is the first phase of treatment
- Aim: To kill most cancer cells quickly to achieve remission
2) Consolidation Phase:
- This is the second phase of treatment
- Chemotherapy is given to further reduce the tumor cells
3) Maintenance Phase:
- This is the last phase
- Aim: To kill any remaining cancer cells, to prevent relapse
- Given for 2 to 3 years with a combination of drugs:
- Oral MTX (Methotrexate)
- Mercaptopurine
- Vincristine
- Prednisone
CNS Prophylaxis:
- A.L.L. frequently involves the CNS, so prophylactic chemotherapy (Cytarabine + Methotrexate) is given intrathecally, sometimes combined with radiotherapy.
OTHER TREATMENTS
- Stem cell transplant (if it recurs after chemo)
- Gene therapy
- Local radiotherapy (for bone pain due to mets)
PROGNOSIS
-
Prognosis is very good in children:
- Cure rate is almost 90% in children
- Survival rate in adults is not so good (30%)
-
With new treatments, cure is possible in some adults also.